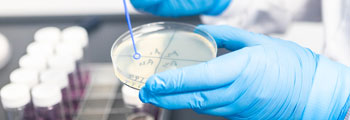
Small-environmental-hygiene-and-product-swabs environmental hygiene and product swabs

Product
We offer a variety of testing on a wide range of matrices including fish, meat, ready to buy products. We also offer product shelf-life testing.
Test
Total Viable Count at 37°C
Total Viable Count at 30°C
Total Viable Count at 22°C
pH
Coliforms
E. coli
Coagulase positive Staphylococci (37°C)
Presumptive Enterobacteriaceae
Pseudomonas Species
Salmonella species (Précis method)
Listeria Species (Rapid L Mono method)
Listeria monocytogenes DNA (PCR Method)
Small environmental hygiene and product swabs
We offer environmental and product swabbing to help you maintain regulatory compliance.
Test
Total Viable Count at 37°C
Total Viable Count at 30°C
Total Viable Count at 22°C
Coliforms
E. coli
Coagulase positive Staphylococci (37°C)
Presumptive Enterobacteriaceae
Pseudomonas Species
Salmonella species (Précis method)
Listeria Species (Rapid L Mono method)
Listeria species (Précis Method)
Listeria monocytogenes DNA (PCR Method)

Large environmental hygiene and product swabs
We offer environmental and product swabbing to help you maintain regulatory compliance.
Test
Salmonella species (Précis method)
Listeria Species (Rapid L Mono method)
Listeria species (Précis Method)
Listeria monocytogenes DNA (PCR Method)

Potable Water and Ice
We offer testing of drinking water, swimming pool water and commercially produced ice. Helping you comply with drinking water regulations.
Test
Total Viable Count at 37°C
Total Viable Count at 22°C
pH
Coliforms
E. coli
Pseudomonas aeruginosa
Salmonella species (Précis method)
Listeria Species (Rapid L Mono method)
Listeria monocytogenes DNA (PCR Method)
Legionella species
Intestinal Enterococci

Shellfish
We offer testing for a variety of shellfish species including mussels and oysters.
Test
E. coli (MPN method)
Salmonella species (Précis method)
Sensoreal (Rapid detection of PSP, ASP and DSP toxins)

Sea Water/Natural Waters
We offer testing of sea and fresh water to help with environmental monitoring.
Test
Total Viable Count at 37°C
Total Viable Count at 22°C
pH
Total Coliforms
E. coli
Faecal Coliforms
Listeria Species (Rapid L Mono method)
Salinity
Conductivity
Intestinal Enterococci

Dairy
We offer testing of milk products and have on-site pasteurization capabilities.
Test
Total Viable Count at 30°C
E. coli
Presumptive Enterobacteriaceae
Thermoduric Tests
The laboratory is UKAS accredited, which underpins Shetland Aanalytical Services’ very high standard of service.

RSA Scheme for Marks & Spencer and Tesco
